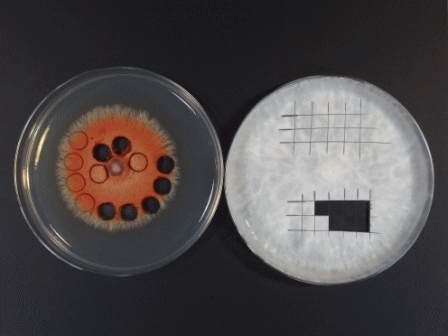
菌体ディスクの切り出し例. （左）ストローによる打ち抜き. （右）メスによる切り出し.

◆◇◆ ━━━━━━━━━━━━━━━━━━━━━━━━━━━ ◆◇◆
NBRCニュース No. 25(2014.2.3)
◆◇◆ ━━━━━━━━━━━━━━━━━━━━━━━━━━━ ◆◇◆
NBRCニュース第25号をお届けします。今号は微生物あれこれ、微生物の保存
法、NITEが解析した微生物ゲノム、特許微生物寄託のイロハの4つの連載をお
届けします。最後までお読みいただければ幸いです。前号でご案内いたしまし
たNBRC微生物実験講習会は、おかげさまで各回とも満員になりましたので、申
込みを締め切りました。多数のご応募をいただき、ありがとうございました。
本講習会は不定期に実施しておりますが、次回の開催が決まりましたら、NBRC
ニュースなどでご案内いたします。
(等幅フォントでご覧ください)
======================================================================
内容
======================================================================
1.新たにご利用可能となった微生物株(2013年11月29日~2014年1月17日)
2.微生物あれこれ(22)
標準となる微生物
3.微生物の培養法(13)
糸状菌の凍結保存法の詳細
4.NITEが解析した微生物ゲノム(12)
アクチノプラネス属放線菌Actinoplanes missouriensis NBRC 102363
5.特許微生物寄託のイロハ(6)
分譲請求ってどうやるの?
6.平成26年度海外微生物合同探索の公募のお知らせ
7.NITEバイオテクノロジーセンター展示のお知らせ
8.公開システムのメンテナンスに関するお知らせ
======================================================================
1.新たにご利用可能となった微生物株(2013年11月29日~2014年1月17日)
======================================================================
酵母 1株、糸状菌 11株、細菌 17株、アーキア 3株、藻類 2株を新たに公開
しました。
【新規公開株一覧】
https://www.nite.go.jp/nbrc/cultures/nbrc/new_strain/new_dna.html
======================================================================
2.微生物あれこれ(22)
標準となる微生物 (鈴木健一朗)
======================================================================
皆様は表題からJISや薬局方に指定された微生物株を想像されたかもしれま
せんが、分類学的基準株も標準となる微生物です。分類学的基準株は新種提案
の時に記載した性質を示す種の基準として指定するもので、分離株の同定や分
類体系の研究において比較の対象や種の代表として使われ、これらの保存と提
供はカルチャーコレクション(生物遺伝資源を保存提供する機関)の重要な役
割のひとつです。今回は、分類や同定の指標となる試験や成分の標準としての
コレクションに保存されている株の利用法をご紹介いたします。
一般に分離された細菌やアーキアの株を同定するとき、まず16S rRNAの塩基
配列を決定し、近縁の比較対象となる分類群を絞ります。16S rRNA塩基配列の
比較には公共データベースの塩基配列を使うのが一般的で、それらの菌株自体
は必要としません。一方、表現性状である生理・生化学性状などを調べる場合
には、文献との比較だけでは結果が同一かどうかの判断は難しいので、比較す
べき株も同時に培養して試験する必要があります。また、オキシダーゼ試験や
硝酸塩の還元など、試験によっては陽性と陰性の対照を用いて、試験の妥当性
を確認する必要があります。近縁の菌群との比較だけでは、すべて同じ結果と
なった時に実験の間違いがあっても気づくことができないためです。そのほか
培養物の活性によってデータが変わりやすいことにも注意しなければなりませ
ん。コレクションの株は、これらの試験の対照としてお使いいただけます。
一方、細胞成分を利用する化学分類学的指標は、培養物の活性に依存しない
長所を持っています。したがって、分類群の性状の記載には重要な指標といえ
ます。細菌の場合、細胞壁ペプチドグリカンのアミノ酸組成(配列)や、菌体
脂肪酸や呼吸鎖電子伝達系のイソプレノイドキノンなどの脂質成分に多様性が
見いだされるので、化学分類学的指標としてよく使われています。しかし、指
標として用いられる分子種の中には、ガスクロマトグラフや液体クロマトグラ
フ(HPLC)の保持時間は異なりますが、分子量は同じであるため、質量分析で
は区別がつかないものが多くあります。また、これらの分子種の同定には分析
化学的に標準物質が必要となりますが、それらの多くは試薬として市販されて
いませんし、仮に市販されていたとしても高価です。このように分子種を同定
する場合は、文献などを調査して、指標となる分子種および関連する分子種を
もつ菌株から試料を調製し、分析の際にその成分を標準として利用していただ
くと、分子種の同定が容易でかつ安価に行えます。
原核生物の新しい分類群が発表される学術雑誌International Journal of
Systematic and Evolutionary Microbiology (IJSEM誌)では、新種などの記載
に極性脂質の薄層クロマトグラフィーのパターンを要求していますが、これに
ついても典型的なパターンや発色について、コントロールとなる菌株を用いて
確認されることをお勧めします。
最後に、化学分類の指標となる成分の標準として用いる菌株は、分類学的に
近縁なものからだけではなく、組成が単純で培養が容易なものから選ぶことを
お勧めします。そして、菌株の選定では種名だけに頼らず、その成分がHPLCだ
けではなく質量分析等を用いて解析されていることを文献でご確認ください。
皆様のご研究にコレクションの株が役に立つことを願っております。
======================================================================
3.微生物の保存法(13)
糸状菌の凍結保存法の詳細 (稲葉重樹)
======================================================================
凍結保存法は糸状菌(カビやキノコ)の菌株を長期間保存する方法として広
く用いられています。NBRCでも胞子形成が不十分な糸状菌株を凍結保存してお
り、その手法をNBRCニュース第3号「微生物の保存法 (2)、一般的な糸状菌の
凍結保存法」で紹介しています。その後、方法の詳細について多くのご質問を
いただいていますので、前回の記事に補足する形で凍結保存法を糸状菌に適用
する際のコツや留意点を解説します。
◆ 菌株の培養
栄養寒天培地は各菌株の生育が良好なものを選択します。培地上で胞子形成
する菌株では胞子を多く作る培地に培養して胞子ごと凍結保存する方が解凍後
の生残性が向上します。
◆ 菌体ディスクの切り出し
NBRCでは滅菌済みストローを用いて寒天ごと菌体を打ち抜く方法を採用して
います。ストローは市販の耐熱性のものを利用します。直径5~8 mmのものを
10~15 cm程度の使いやすい長さに切りそろえ、滅菌バックなどに封入してオ
ートクレーブ滅菌した後で乾燥させます(図1)。コルクボーラーを火炎滅菌
して用いることもできます。滅菌した外科用メスを用いて菌体を井桁状に切り
出す方法も簡便です(図2)。

図1.滅菌バックを用いたストローの滅菌例
図2.菌体ディスクの切り出し例
(左)ストローによる打ち抜き. (右)メスによる切り出し.
◆ 菌体ディスクのピックアップ 凍結保護液(約1 ml)の入ったオートクレーブ滅菌済みのポリプロピレン製 凍結保存用チューブ(2 ml容)に、白金耳や柄付き針を用いて打ち抜いた寒天 ディスクを入れます(1~5枚程度)。多数の菌株を一度に保存する際は、滅菌 竹串(実験器具として市販されています)を用いると火炎滅菌の操作を省略で きて便利です。 ◆ 凍結保護液 糸状菌では、10%グリセロールや10%ジメチルスルホキシド(DMSO)水溶液が よく用いられます。グリセロールやDMSOに糖などの物質を添加することにより 保存性が向上する場合があることが知られており、NBRCでは10%グリセロール に5%(w/v)のトレハロース(食品添加物として市販されている安価なもの)を 加えています。 ◆ 保存温度 長期保存には-70℃以下で凍結状態を維持することが好ましいとされていま す。-20~-40℃のフリーザーで保存した場合は、扉の開閉による温度上昇に よって融解・凍結が繰り返されたり、氷の結晶構造が変化したりすることによ り菌体が損傷し、生残性が低下することがあります。-80℃以下のフリーザー か、液体窒素タンクの気相(-150~-180℃程度)での保存が有効です。卵菌 類や菌根形成性の担子菌類などは、-80℃では長期間の保存に耐えない場合が ありますので、液体窒素タンクの気相での保存が必要です。 ◆ 凍結方法 ほとんどの糸状菌の場合、菌体の入ったチューブを直接フリーザーや液体窒 素タンクに移して凍結しても問題はありません。しかし、一部の凍結感受性の 菌株は急冷によって死滅することがあります。これらの菌株には、チューブを 4~7℃程度で30分~一晩静置して凍結保護液を菌体内に浸透させた後に、-30 ℃程度で凍結してからフリーザーや液体窒素タンクの気相に移す2段階凍結法 や、発泡スチロールや2-プロパノールを利用した凍結保存ユニット(例:ミス ターフロスティー、NALGENE)にチューブを入れて-70~-80℃で緩慢凍結す る方法が有効です。プログラムフリーザー(例:IceCube15M、SY-LAB)を用い ればより厳密な温度調節が可能です。緩慢凍結を行い液体窒素タンクの気相で 保存することで凍結感受性の菌株のほとんどは長期保存が可能となりますが、 一部の担子菌類(フクロタケ属Volvariellaや外生菌根菌類)の菌株では死滅 する場合があります。最近、パーライトを培養基材として用いる凍結法がこれ らの担子菌類にも有効であることが報告されており(Sato et al. 2012)、更な る改良が期待されます。 ◆ 復元方法 チューブから菌株を復元する際はウォーターバスなどを用いて30~37℃で急 速に解凍します。自然解凍では多くの糸状菌類で生残性が低下します。氷の結 晶が融解したら(-80℃保存では3分、-170℃では5分程度)ただちに適切な 培地にチューブ内の菌体ディスクを接種します。 【文献】 Sato M. et al. (2012) CryoLetters 33: 86-94. ====================================================================== 4.NITEが解析した微生物ゲノム (12) アクチノプラネス属放線菌Actinoplanes missouriensis NBRC 102363 (木村明音) ====================================================================== Actinoplanes missouriensis NBRC 102363 (= 431)は、本種の分類学的基準 株で、種名が示すようにアメリカのミズーリ州のハミルトン近くの堆肥土壌か ら分離されました。本株は糖質変換に利用されるキシロースイソメラーゼを生 産するほか、フラボノイドや天然ゴムなどに対して高い分解活性を持っていま す。Actinoplanes属は土壌に生息する放線菌で、気菌糸は作りませんが、球状 の胞子嚢を形成し、水に接触すると胞子嚢が破れ、走化性を示す運動性胞子を 放出するという特徴があります。属名もこの特徴に由来しており、「actino」 は「放射状の構造」を、「planes」は「歩き回る人あるいは動物」を意味し、 「Actinoplanes」で「泳ぎ回る胞子をもつ放線菌」を表すことを意図していま す。またActinoplanes属には、様々な抗生物質、酵素、その他生理活性物質を 生産する株が属しているため、そのゲノム情報は二次代謝産物の合成機構の解 明や、二次代謝産物や酵素の探索に役立つことが期待されます。 ゲノム解析結果から、A. missouriensis NBRC 102363は約8.7Mbの環状染色 体を持つことが明らかになりました。本属が含まれるMicromonosporaceae科の Micromonospora属やSalinispora属よりもゲノムサイズが大きく、全部で8204 個の遺伝子(8125個のタンパク質コード遺伝子と79個のRNA遺伝子)が予測さ れました。タンパク質コード遺伝子は、半分強の4539個の機能が予測されまし たが、残りは未知遺伝子でした。 本株のゲノム情報はデータベースDOGANで公開しております。皆様の研究開 発にご活用いただければ幸いです。


Actinoplanes missouriensis 431T 電子顕微鏡写真(早川教授(山梨大学)提供) 染色体ゲノム 【詳細】 http://www.bio.nite.go.jp/dogan/top 【文献】 Yamamura et al. (2012). Stand. Genomic Sci. 7: 294-303. ====================================================================== 5.特許微生物寄託のイロハ (6) 分譲請求ってどうやるの? (村松由貴) ====================================================================== 公開済みの特許情報を確認するために、特許微生物株の分譲を依頼すること ができます(特許微生物株では「分譲請求」と呼びます)。特許微生物株の分 譲請求手続きや手数料については、ホームページでご案内しておりますので、 本稿では手続きに関してもう少し細かい内容をご紹介します。 特許微生物株は、公開済みの特許情報に基づいて分譲請求されることが前提と なっています。従って、特許微生物株の分譲請求は、受託番号(FERMもしくは NITEから始まる番号)に基づいて行ってください。識別の表示(いわゆる菌株 番号)による分譲請求には応じることができません。 特許微生物株の分譲請求者は(1) 寄託者本人、(2) 寄託者の承諾を得た者、 (3) 法令上の有資格者のいずれかである必要があります。また分譲請求者は、 この3種類のうちで自分が該当する者に応じた書式を用いて分譲請求をしなけ ればなりません。特に、(2) 寄託者の承諾を得た者、または(3) 法令上の有資 格者として分譲請求する場合は、所定の分譲請求書に寄託者の承諾または工業 所有権庁(日本特許株の場合は特許庁)の資格証明を得てください。承認を受 けた分譲請求書と微生物の使用に関する承諾書をあわせてお送りいただくこと になります。使用目的にも制限があり、分譲を受けた特許微生物株は、その微 生物に係る発明の試験・研究のためだけに使用できます。また、分譲を受けた 者は、その微生物を第三者に利用させてはなりません。 分譲請求した後に、「いつ頃微生物株が届くのか?」というお問合せをいた だくことがあります。手続きの大まかな流れは、分譲請求書受理 -> 生存確認 試験->(試験結果に問題がなければ)請求書の送付 -> ご入金 -> 微生物の送 付、となります。書類受付等の事務処理は基本的に当日中に行いますので、分 譲請求されてから微生物がお手元に届くまでにかかる時間は、生存確認試験に 必要な期間とご入金のタイミングによります。目安としては、生育に約2週間 かかる微生物では、お手元に微生物が届くのには少なくとも3週間はかかりま す。 【分譲請求】 ・https://www.nite.go.jp/nbrc/patent/furnishing/index.html ====================================================================== 6.平成26年度海外微生物合同探索の公募のお知らせ ====================================================================== 平成26年度に実施予定の「海外における生物遺伝資源の保全と持続可能な利 用に関する共同事業」に関して共同事業先を公募いたします。 詳細は以下をご覧ください。 モンゴル: https://www.nite.go.jp/nbrc/global/information/collabo_MN_20140121.html ベトナム: https://www.nite.go.jp/nbrc/global/information/collabo_Vietnam_20140121.html ミャンマー: https://www.nite.go.jp/nbrc/global/information/collabo_MM_20140121.html ====================================================================== 7.NITEバイオテクノロジーセンター展示のお知らせ ====================================================================== 以下に出展いたします。お立ち寄りいただいた皆様からのご相談やご質問に もお答えします。是非お越しください。 日本農芸化学会2014年度大会 日程:2014年3月27日(木)~30日(日) 場所:明治大学生田キャンパス http://www.jsbba.or.jp/2014/ 日本化学会第94春季年会 日程:2014年3月27日(木)~30日(日) 場所:名古屋大学東山キャンパス http://csj.jp/nenkai/94haru/ ====================================================================== 8.公開システムのメンテナンスに関するお知らせ ====================================================================== 公開システムのメンテナンスに伴い、以下の日時に一部のWebサービスを停 止させていただきます。日程は変更する場合がありますので、詳細は以下のペ ージをご覧ください。 https://www.nite.go.jp/nbrc/information/maintenance/maintenance.html 日時:2014年2月 6日(木)10時30分~17時00分 2014年2月27日(木)10時30分~15時00分 2014年3月14日(金)18時15分~3月16日(日)19時00分 2014年3月11日(火)10時00分~17時00分 2014年3月26日(水)10時30分~17時00分 ====================================================================== 編集後記 ====================================================================== 子供の頃、「外から帰ってきたら、うがい手洗いをしましょう」とよく言わ れましたが、大人になった今も、なさっていますか?私はいつの頃からか、う がい手洗いが癖になり、出勤した時や家に帰ってきた時だけでなく、友人の家 を訪問した際も洗面台を借りてうがい手洗いをします。おかげで、ここ数年か ぜで病院のお世話にはなっていません。かぜがはやっていますが、みなさまも お体に気をつけてください。ちなみに、私は外から帰ってきたら足も洗ってい ます。これは水虫予防です。(KY) ◆◇◆ ━━━━━━━━━━━━━━━━━━━━━━━━━━━ ◆◇◆ ・受信アドレス変更、受信停止は以下のサイトからお手続きください。 https://www.nite.go.jp/nbrc/cultures/others/nbrcnews/nbrcnews.html ・NBRCニュースは配信登録いただいたメールアドレスにお送りしております。 万が一間違えて配信されておりましたら、お手数ですが、下記のアドレスに ご連絡ください。 ・ご質問、転載のご要望など、NBRCニュースについてのお問い合わせは、下記 のアドレスにご連絡ください。 ・掲載内容は予告なく変更することがございます。掲載内容を許可なく複製・ 転載されることを禁止します。 ・偶数月の1日(休日の場合はその前後)に配信します。第26号は3月31日に配 信予定です。 編集・発行 独立行政法人製品評価技術基盤機構(NITE)バイオテクノロジーセンター NBRCニュース編集局(nbrcnews@nite.go.jp) ◆◇◆ ━━━━━━━━━━━━━━━━━━━━━━━━━━━ ◆◇◆








